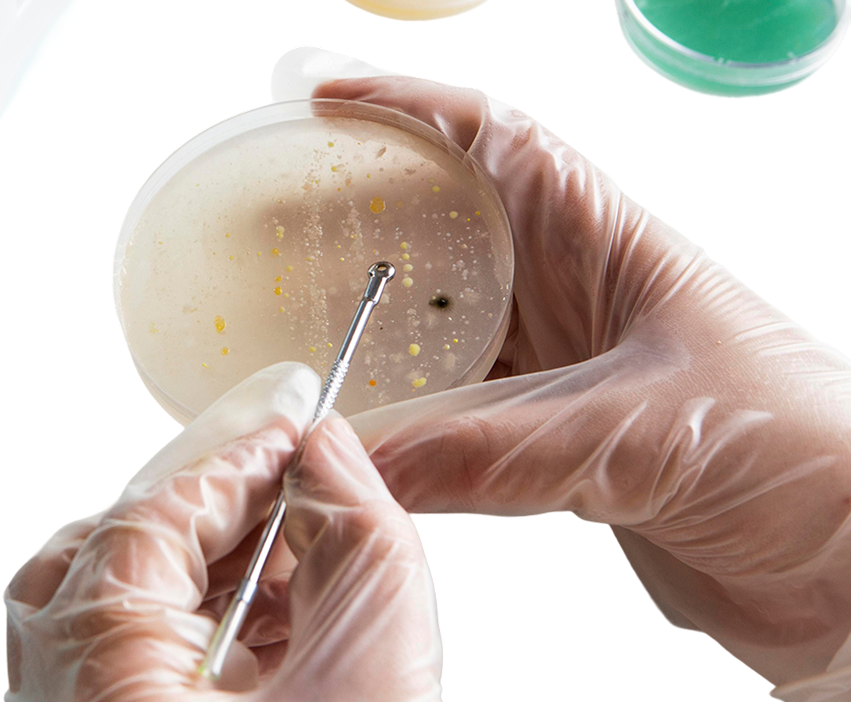
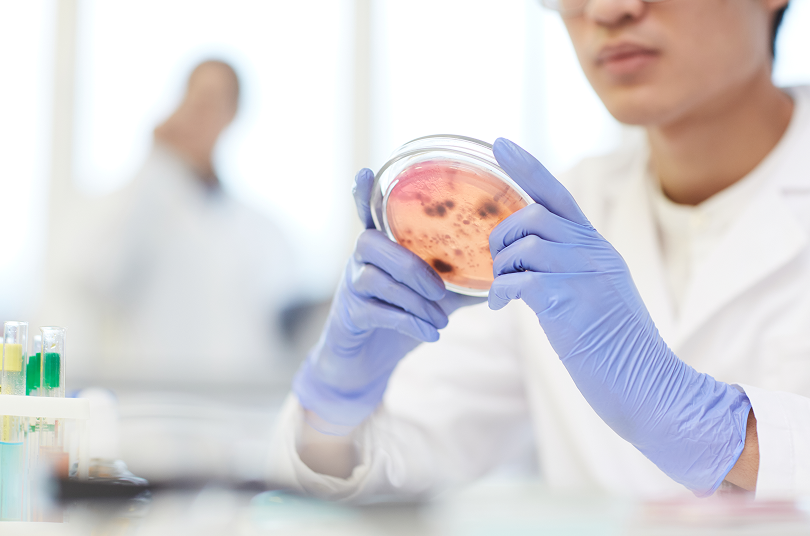

At Vitality Healthcare Group, we specialize in regenerative stem cell therapy designed to support healing, reduce inflammation, and improve overall function. Our focus is not cosmetic treatments, but medical regenerative care for patients seeking relief from chronic pain, autoimmune conditions, and degenerative disorders.
Stem cell therapy works by supporting the body’s natural repair mechanisms. This approach may help improve joint function, reduce pain, and enhance quality of life without invasive surgery. Our medical team provides personalized regenerative care tailored to each patient’s condition and health goals.
Stem cell therapy is an advanced regenerative treatment that supports tissue repair, reduces inflammation, and promotes cellular regeneration. This therapy is used to address a wide range of medical conditions affecting joints, muscles, nerves, and immune function.
Patients commonly seek stem cell therapy for:
• Joint pain and degeneration
• Arthritis and inflammation
• Autoimmune conditions
• Chronic pain
• Sports injuries
• Degenerative conditions
• Tissue damage and slow healing
This regenerative approach focuses on improving function and supporting long-term recovery rather than masking symptoms.
Stem cell therapy may help support recovery and symptom improvement for patients experiencing:
Joint and Orthopedic Conditions
Autoimmune and Inflammatory Conditions
Degenerative and Chronic Pain Conditions
Stem cells play a critical role in the body’s repair system. They help support the regeneration of damaged tissues and may assist in reducing inflammation at the source.
Potential benefits include:
• Reduced joint pain and inflammation
• Improved mobility and flexibility
• Support for tissue repair and regeneration
• Improved overall function
• Reduced reliance on invasive procedures
Every patient responds differently, and our team carefully evaluates your condition to determine if regenerative therapy is appropriate.
Patients trust Vitality Healthcare Group because we focus on regenerative medical care designed to support healing and recovery.
Medical-Focused Regenerative Therapy
We specialize in regenerative treatments focused on healing, pain relief, and functional improvement.
Personalized Treatment Plans
Each therapy plan is customized based on your condition and health goals.
Experienced Regenerative Care Team
Our medical team focuses on providing professional, patient-centered regenerative care.
Non-Surgical Treatment Option
Stem cell therapy may offer a non-invasive alternative for patients seeking relief without surgery.







